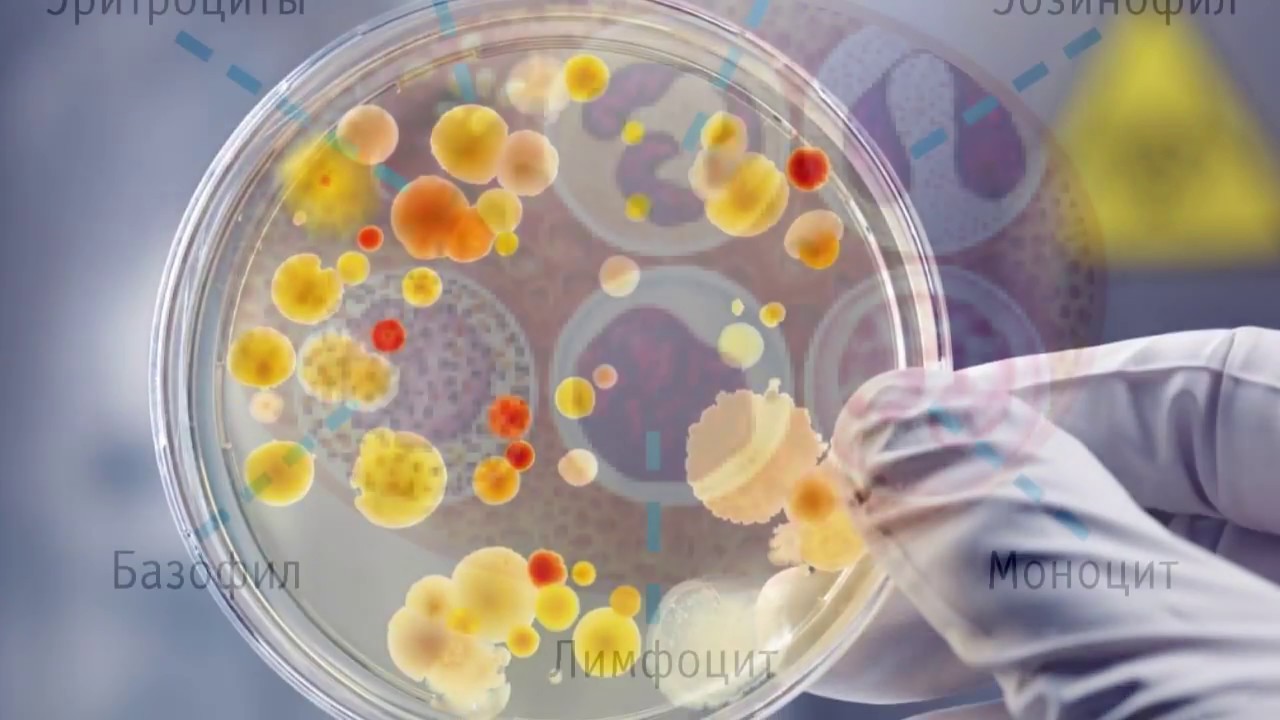
Анализы Крови: ДИФФЕРЕНЦИАЛЬНЫЙ АНАЛИЗ КРОВИ (нейтрофилы/базофилы/лимфоциты и моноциты)

Моноцитоз — это повышение уровня моноцитов в крови, важный лабораторный показатель, указывающий на различные физиологические и патологические процессы. Понимание причин абсолютного и относительного моноцитоза у взрослых помогает врачам точнее диагностировать заболевания, оценивать состояние иммунной системы и принимать решения о лечении. В статье рассмотрим основные причины моноцитоза, что поможет читателям лучше понимать результаты анализов и их значение для здоровья.
Значение в лабораторных анализах
Моноциты могут находиться в кровеносной системе в течение нескольких дней. После этого они перемещаются в соседние ткани, где начинают процесс созревания. В этом процессе они трансформируются в гистоциты, которые представляют собой особую форму тканевых макрофагов.
Показатель уровня моноцитов является важным критерием, на который обращают внимание специалисты при анализе крови. У взрослых повышение этого уровня может указывать на наличие различных заболеваний. Среди них можно выделить:
- дерматологические заболевания;
- инфекционные болезни;
- гранулематозные состояния.
Особенно стоит отметить такие заболевания, как волчанка и ревматоидный артрит.

Врачи отмечают, что моноцитоз, как абсолютный, так и относительный, может быть вызван различными факторами. Абсолютный моноцитоз, характеризующийся повышением количества моноцитов в крови, часто связан с инфекциями, особенно вирусными, такими как ВИЧ или гепатит. Также он может указывать на хронические воспалительные процессы, такие как болезнь Крона или ревматоидный артрит. Относительный моноцитоз, в свою очередь, может возникать при снижении других типов лейкоцитов, что часто наблюдается при острых инфекциях или стрессовых состояниях. Врачи подчеркивают важность комплексного подхода к диагностике, так как моноцитоз может быть симптомом более серьезных заболеваний, требующих внимательного наблюдения и лечения.
Роль в организме
Моноциты — это разновидность белых кровяных клеток, относящихся к фагоцитам. Это означает, что они активно участвуют в борьбе с бактериями, вирусами и другими чуждыми веществами, проникающими в организм. Однако их функции не ограничиваются только этим. Моноциты помогают восстанавливать пространство после гибели лейкоцитов, что способствует снижению воспалительных процессов и ускоряет регенерацию тканей. Кроме того, они играют важную роль в выработке интерферона и в профилактике онкологических заболеваний.

| Причина моноцитоза | Тип моноцитоза | Дополнительные комментарии |
|---|---|---|
| Инфекционные заболевания | ||
| Бактериальные инфекции (туберкулез, бруцеллез, сифилис, подострый бактериальный эндокардит) | Абсолютный и относительный | Часто сопровождаются лихорадкой, интоксикацией. |
| Вирусные инфекции (инфекционный мононуклеоз, корь, краснуха, цитомегаловирусная инфекция) | Абсолютный и относительный | Могут быть атипичные мононуклеары. |
| Грибковые инфекции (гистоплазмоз, кокцидиоидомикоз) | Абсолютный и относительный | Редкие, но серьезные инфекции. |
| Паразитарные инфекции (малярия, лейшманиоз, токсоплазмоз) | Абсолютный и относительный | Часто связаны с путешествиями в эндемичные регионы. |
| Гематологические заболевания | ||
| Миелодиспластические синдромы (МДС) | Абсолютный и относительный | Могут прогрессировать в острый миелоидный лейкоз. |
| Хронический миеломоноцитарный лейкоз (ХММЛ) | Абсолютный | Характеризуется стойким моноцитозом > 1 x 10^9/л и > 10% от лейкоцитов. |
| Острый миелоидный лейкоз (ОМЛ) с моноцитарной дифференцировкой (М4, М5) | Абсолютный | Агрессивное заболевание, требующее немедленного лечения. |
| Лимфомы (болезнь Ходжкина, неходжкинские лимфомы) | Относительный (реже абсолютный) | Могут быть связаны с воспалительным процессом в опухоли. |
| Множественная миелома | Относительный (реже абсолютный) | Моноцитоз может быть маркером активности заболевания. |
| Аутоиммунные и воспалительные заболевания | ||
| Системная красная волчанка (СКВ) | Относительный | Моноциты участвуют в патогенезе аутоиммунных реакций. |
| Ревматоидный артрит | Относительный | Моноциты играют роль в воспалении суставов. |
| Воспалительные заболевания кишечника (болезнь Крона, язвенный колит) | Относительный | Моноциты участвуют в хроническом воспалении слизистой оболочки. |
| Саркоидоз | Абсолютный и относительный | Характеризуется образованием гранулем. |
| Другие причины | ||
| Восстановление после миелосупрессии (химиотерапия, лучевая терапия) | Абсолютный | Признак восстановления костного мозга. |
| Прием некоторых лекарственных препаратов (кортикостероиды, факторы роста) | Относительный | Влияние на гемопоэз. |
| Состояние после спленэктомии | Относительный | Селезенка является местом депонирования моноцитов. |
| Стресс, физическая нагрузка | Относительный | Временное повышение, не имеет клинического значения. |
| Курение | Относительный | Хроническое воспаление, связанное с курением. |
Причины увеличения
Моноцитоз делится на два вида: абсолютный и относительный. В случае относительного моноцитоза наблюдается снижение не только уровня моноцитов, но и других типов фагоцитов. Абсолютный моноцитоз, напротив, характеризуется увеличением только моноцитов, что может происходить на фоне лимфоцитопении или нейтропении. К числу причин моноцитоза у взрослых относятся:
- инфекционные заболевания, вызванные вирусами и бактериями;
- нарушения в системе кроветворения;
- некоторые физиологические состояния, например, завершение менструации у женщин;
- прием пищи.
Похожая ситуация наблюдается и у детей младше 7 лет, когда моноцитоз возникает в результате попадания инородных тел в дыхательные пути.
Моноцитоз также может проявляться после недавних хирургических операций. В некоторых случаях он наблюдается в процессе восстановления после инфекционных заболеваний.
Во время беременности
Во время беременности наблюдаются определенные изменения в уровнях моноцитов, и не следует сразу воспринимать это как признак болезни. Это явление является естественной реакцией иммунной системы на новые условия. Моноциты в основном вырабатывают цитокины — вещества, обладающие противовоспалительными свойствами. Хотя эти элементы крови эффективно борются с бактериями, их повышенное количество может привести к ослаблению защиты от вирусов. Поэтому будущим мамам важно регулярно проходить анализы на наличие различных вирусов. Принятые нормы моноцитов могут изменяться в зависимости от триместра беременности:
- 1 триместр — в среднем 3,9%;
- 2 триместр — 4%;
- 3 триместр — 4,5%.
Показатели у детей
В большинстве случаев моноцитоз у детей указывает на наличие вирусной инфекции. Дети подвержены таким заболеваниям гораздо чаще, чем взрослые. Поэтому увеличение уровня моноцитов говорит о том, что организм в данный момент борется с инфекцией. Рост количества этих клеток в крови также может быть связан с заражением паразитами:
- аскаридоз;
- энтеробиоз;
- другие виды глистных инвазий.
Моноцитоз исчезает, как только удается избавиться от паразитов.
Несмотря на достижения в профилактике туберкулеза, повышение уровня моноцитов должно вызывать беспокойство у родителей. В таком случае им рекомендуется обратиться к фтизиатру для дополнительной консультации.
Диагностические мероприятия
Моноцитоз не следует рассматривать как отдельный диагноз. Для более точной оценки состояния пациента необходимо изучить уровень других лейкоцитов и форменных элементов крови. Это позволяет определить стадию заболевания, оценить работу иммунной системы и эффективность назначенного лечения. Возможные комбинации:
- Повышенные уровни моноцитов и лимфоцитов. Это может указывать на наличие вирусной инфекции, затрагивающей дыхательные пути. При этом уровень нейтрофилов может снижаться.
- Одновременное увеличение моноцитов и базофилов. Эти клетки в первую очередь появляются в местах воспаления. Иногда их рост может быть связан с длительным применением гормональных препаратов.
- Повышение уровня моноцитов в сочетании с эозинофилией часто является следствием аллергической реакции. Это распространенный случай при заражении микоплазмой или глистами. В таких ситуациях могут наблюдаться характерные симптомы, такие как сухой кашель без хрипов в легких и других клинических проявлений.
Компоненты лейкоцитарной формулы могут периодически заменять друг друга, чтобы компенсировать недостаток определенных функций. В большинстве случаев наблюдаются лишь незначительные отклонения, поэтому адекватное лечение обычно приносит хорошие результаты. Терапию рекомендуется проводить в течение 1-2 недель. Поводом для беспокойства о серьезных заболеваниях может служить только длительный моноцитоз, сопровождающийся изменениями в показателях других лейкоцитов.

Тактика лечения, прогноз и профилактика
Терапия выбирается в зависимости от причины, вызвавшей увеличение уровня моноцитов. Обязательным этапом является сдача анализа крови, который следует регулярно проводить для оценки эффективности лечения. Если в результате диагностики не выявлено никаких отклонений, то лечение не требуется.
При установлении диагноза моноцитоз не следует заниматься самолечением ни взрослым, ни детям. Это состояние является симптомом различных заболеваний, поэтому дальнейшие шаги в лечении зависят от результатов обследования. Важно, чтобы в этот период рацион был сбалансированным и включал все необходимые организму вещества. Можно дополнительно принимать витамины. Рекомендуется акцентировать внимание на овощах, фруктах, молочных продуктах и других источниках белка.
Регулярные физические нагрузки также играют важную роль. Прогулки на свежем воздухе приносят значительную пользу.
Если моноцитоз вызван бактериальной инфекцией, потребуется назначение антибиотиков. В случае вирусной природы проблемы назначаются противовирусные средства. У детей уровень моноцитов может повышаться во время прорезывания зубов.
Прогноз зависит от специфических характеристик заболевания, вызвавшего увеличение моноцитов. Основной мерой профилактики является предотвращение болезней, которые могут привести к данному состоянию. Если избежать заболевания не удалось, важно своевременно обратиться к врачу. При правильно подобранном лечении прогноз обычно благоприятный.

Связь с хроническими заболеваниями
Хронические заболевания играют значительную роль в развитии как абсолютного, так и относительного моноцитоза у взрослых. Моноциты — это тип белых кровяных клеток, которые отвечают за иммунный ответ организма, и их уровень может увеличиваться в ответ на различные патологические состояния. При хронических заболеваниях, таких как инфекционные, воспалительные и аутоиммунные процессы, наблюдается постоянная стимуляция иммунной системы, что приводит к повышению количества моноцитов в крови.
Одним из наиболее распространенных примеров является хроническая инфекция, такая как туберкулез или ВИЧ. Эти заболевания вызывают длительное воспаление, что приводит к увеличению продукции моноцитов в костном мозге. В результате этого наблюдается абсолютный моноцитоз, когда количество моноцитов в крови превышает норму. Кроме того, при таких инфекциях может наблюдаться относительный моноцитоз, когда общее количество лейкоцитов увеличивается, а моноциты составляют большую долю от общего числа белых кровяных клеток.
Аутоиммунные заболевания, такие как системная красная волчанка или ревматоидный артрит, также могут быть связаны с моноцитозом. В этих случаях иммунная система ошибочно атакует собственные ткани организма, что приводит к хроническому воспалению. Это воспаление, в свою очередь, вызывает увеличение продукции моноцитов, что может проявляться как в абсолютном, так и в относительном моноцитозе.
Кроме того, хронические заболевания печени, такие как цирроз или гепатит, могут также способствовать развитию моноцитоза. Печень играет ключевую роль в метаболизме и детоксикации, и при ее повреждении происходит активация иммунных механизмов, что может привести к увеличению уровня моноцитов.
Важно отметить, что моноцитоз может быть не только следствием хронических заболеваний, но и их предшественником. Увеличение уровня моноцитов может указывать на активизацию воспалительных процессов, что требует дальнейшего обследования и диагностики для выявления основного заболевания.
Таким образом, связь между хроническими заболеваниями и моноцитозом является сложной и многофакторной. Понимание этих механизмов имеет важное значение для диагностики и лечения различных патологий, связанных с изменением уровня моноцитов в крови.
Влияние инфекционных процессов
Инфекционные процессы являются одной из основных причин как абсолютного, так и относительного моноцитоза у взрослых. Моноциты — это тип белых кровяных клеток, которые играют ключевую роль в иммунном ответе организма. Их уровень может увеличиваться в ответ на различные инфекционные агенты, включая вирусы, бактерии, грибы и паразиты.
При инфекциях, вызванных бактериями, особенно тех, которые приводят к системным воспалительным реакциям, наблюдается значительное увеличение моноцитов. Например, такие заболевания, как туберкулез, сальмонеллез и бруцеллез, могут вызывать абсолютный моноцитоз. В этих случаях моноциты активно участвуют в фагоцитозе, поглощая и уничтожая патогенные микроорганизмы, а также в секреции цитокинов, которые регулируют воспалительный процесс.
Вирусные инфекции также могут приводить к повышению уровня моноцитов. Например, при инфекционном мононуклеозе, вызванном вирусом Эпштейна-Барр, наблюдается относительный моноцитоз, когда процентное соотношение моноцитов в крови увеличивается на фоне снижения других типов лейкоцитов. Вирусы, такие как ВИЧ, также могут вызывать изменения в уровне моноцитов, что связано с их воздействием на иммунную систему.
Грибковые инфекции, такие как кандидоз, могут также приводить к моноцитозу. Моноциты играют важную роль в защите организма от грибковых патогенов, и их увеличение может быть ответом на необходимость борьбы с инфекцией. Параллельно с этим, некоторые паразитарные инфекции, такие как малярия, могут вызывать относительный моноцитоз, так как организм пытается адаптироваться к присутствию паразитов.
Важно отметить, что моноцитоз может быть не только следствием активной инфекции, но и реакцией на воспалительные процессы, вызванные другими факторами, такими как аутоиммунные заболевания или аллергические реакции. В таких случаях моноциты могут увеличиваться как часть общего воспалительного ответа организма.
Таким образом, инфекционные процессы являются важным фактором, влияющим на уровень моноцитов в крови. Понимание механизмов, лежащих в основе моноцитоза, может помочь в диагностике и лечении различных инфекционных заболеваний, а также в оценке состояния иммунной системы пациента.
Генетические и наследственные факторы
Моноциты — это тип белых кровяных клеток, которые участвуют в иммунном ответе организма, и их уровень может варьироваться в зависимости от множества факторов, включая генетическую предрасположенность.
Некоторые заболевания, связанные с моноцитозом, имеют наследственный характер. Например, наследственные иммунодефициты могут приводить к увеличению числа моноцитов в крови. В таких случаях генетические мутации, влияющие на функционирование иммунной системы, могут вызывать хронические инфекции, что, в свою очередь, приводит к повышению уровня моноцитов как ответной реакции организма.
Кроме того, существуют генетические синдромы, такие как синдром Костмана или синдром Чédiak-Higashi, которые также могут быть связаны с изменениями в количестве моноцитов. Эти синдромы характеризуются различными нарушениями в работе иммунной системы и могут приводить к повышенному уровню моноцитов в периферической крови.
Исследования показывают, что определенные генетические маркеры могут быть связаны с предрасположенностью к заболеваниям, сопровождающимся моноцитозом. Например, полиморфизмы в генах, отвечающих за регуляцию воспалительных процессов, могут влиять на уровень моноцитов. Эти полиморфизмы могут изменять реакцию организма на инфекционные агенты или воспалительные процессы, что приводит к изменению количества моноцитов в крови.
Также стоит отметить, что семейная история заболеваний может быть важным фактором при диагностике причин моноцитоза. Если у близких родственников наблюдаются заболевания, связанные с повышением уровня моноцитов, это может указывать на наличие наследственной предрасположенности. В таких случаях врач может рекомендовать генетическое тестирование для выявления возможных мутаций или полиморфизмов, которые могут быть связаны с данным состоянием.
Таким образом, генетические и наследственные факторы являются важными аспектами, которые необходимо учитывать при оценке причин абсолютного и относительного моноцитоза у взрослых. Понимание этих факторов может помочь в разработке более эффективных стратегий диагностики и лечения, а также в определении риска развития заболеваний, связанных с изменением уровня моноцитов.






